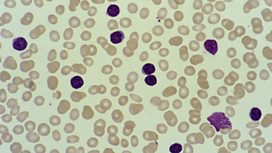

Tuition Fees and Driving Instructors
Jeremy Vine presents news, views and live guests.
Last on
More episodes
Previous
![]()
Jeremy discusses tuition fees, maternity rights, childhood cancer and driving instructors
![]()
Get In Touch
Call, text, or email your views
![]()
The current system of £9,000 per year fees has its critics, but does it work?
![]()
The law says you cannot ask potential female employees if they are planning to have kids.
![]()
In our medical special today we talk to a mum about her child’s leukaemia.
![]()
Driving instructors are warned about 'exploitative' relationships with students.
Clip
-
How do you tell your child that they have cancer?
Duration: 03:35
Music Played
-
Detroit Emeralds
Feel The Need In Me
- Heart Full Of Soul (Various Artists).
- Global Television.
-
Justin Timberlake
Say Something (feat. Chris Stapleton)
- (CD Single).
- RCA.
-
Miami Sound Machine
Dr. Beat
- NOW 1984 (Various Artists).
- NOW.
-
Fleetwood Mac
The Chain
- 50 Years - Don't Stop.
- Warner Bros.
- 010.
-
Clean Bandit
Symphony (feat. Zara Larsson)
- (CD Single).
- Atlantic.
-
Johnny Hates Jazz
Heart Of Gold
- Now That's What I Call Music 12 (Various Artists).
- Now.
- 5.
-
McFadden & Whitehead
Ain't No Stoppin' Us Now
- Now 100 Hits 70s (Various Artists).
- Now.
-
Dua Lipa
IDGAF
- Dua Lipa.
- Warner Bros.
-
Ten Sharp
You
- Ten Sharp.
- Columbia.
-
Mott the Hoople
All The Young Dudes
- The Greatest Hits Of 1972 (Various).
- Premier.
-
Marshmello & Anne-Marie
Friends
- (CD Single).
- Atlantic.
Broadcast
- Mon 19 Feb 2018 12:00ÃÛÑ¿´«Ã½ Radio 2